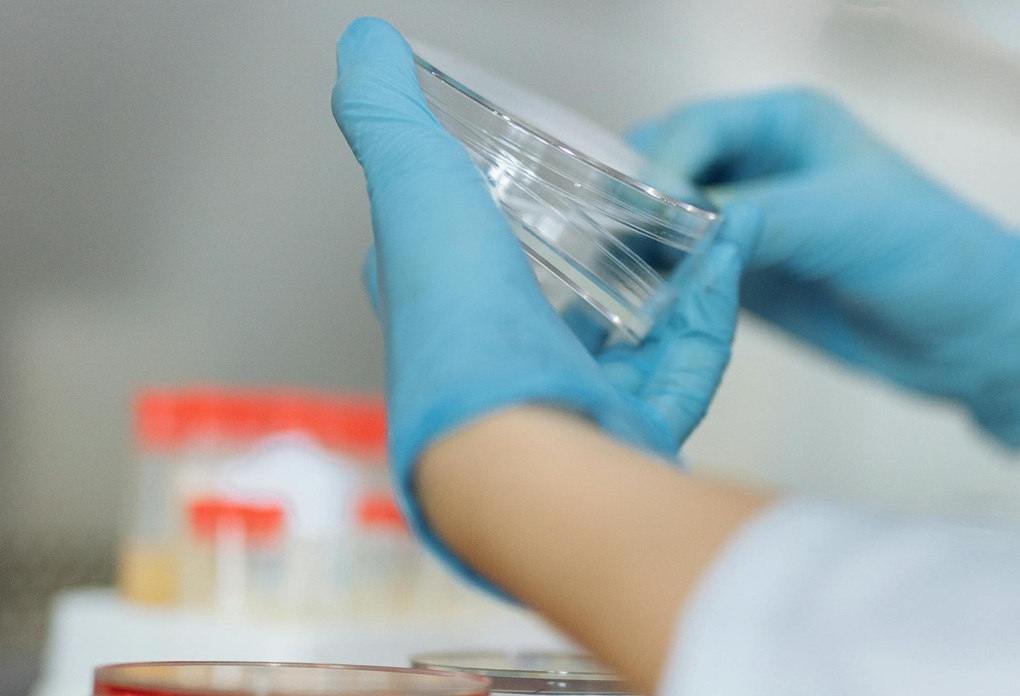

Rukavice koje se koriste pri mjerenju mikroplastike mogu kontaminirati uzorke
Korištenje preporučenih nitrilnih i lateks rukavica očito ne sprječava kontaminaciju uzoraka te utječe na precijenjene razine mikroplastike u okolišu
Nitrilne i lateks rukavice koje znanstvenici koriste tijekom mjerenja mikroplastike mogu dovesti do potencijalnog precjenjivanja tih sitnih onečišćivača, pokazuje novo istraživanje znanstvenika Sveučilišta u Michiganu.
Studija objavljena u časopisu RSC Analytical Methods otkriva da rukavice mogu kontaminirati laboratorijsku opremu koju znanstvenici koriste za mjerenje mikroplastike u zraku, vodi i drugim uzorcima. To znači da bi dosad utvrđene razine mikroplastike u okolišu mogle potencijalno biti pogrešne, odnosno precijenjene.
Istraživačice Sveučilišta u Michiganu, Madeline Clough i Anne McNeil, utvrdile su da se pri mjerenju mikroplastike uzorci mogu kontaminirati stearatima – solima koje imaju važnu ulogu u industriji premaza, boja i lakova. Naime, proizvođači premazuju jednokratne rukavice stearatima kako bi ih lakše odvojili od kalupa u kojima se oblikuju. Međutim, prema istraživačima, stearati su kemijski vrlo slični nekim vrstama mikroplastike i mogu dovesti do lažno pozitivnih rezultata kada istraživači mjere onečišćenje mikroplastikom.
„To ne znači da onečišćenje mikroplastikom ne postoji“, naglašavaju istraživačice. „Možda precjenjujemo mikroplastiku, ali ona uopće ne bi trebala postojati. I dalje je ima puno, i to je problem”, kaže Anne McNeil, glavna autorica studije i profesorica kemije, makromolekularne znanosti i inženjerstva.
„Kao istraživači u okolišu tražimo mikroplastiku, a to je kao da tražimo iglu u plastu sijena, iako uopće ne bi trebalo biti nikakve igle”, dodaje Madeline Clough.
Istraživanje je započelo kada je Clough radila na zajedničkom projektu u kojem su, s ciljem proučavanja mikroplastike u zraku, sudjelovali diplomanti i profesori s odjela kemije, statistike te klimatskih i svemirskih znanosti i inženjerstva na Sveučilištu u Michiganu. Pri uzorkovanju su korištene nitrilne rukavice, kao što s ciljem izbjegavanja kontaminacije uzoraka preporučuju smjernice u literaturi o mikroplastici. No, pri procjeni količine prikupljene mikroplastike, rezultati su bili tisućama puta veći od očekivanih.
„To je dovelo do besciljnog traganja za izvorom kontaminacije jer nam je bilo jasno da podaci nisu točni”, kaže Clough. „Tijekom procesa utvrđivanja uzroka naposljetku smo zaključili da je problem u rukavicama.”
Istraživačice su osmislile eksperiment kako bi utvrdile koliko je taj problem raširen te su testirale sedam različitih vrsta rukavica, uključujući nitrilne, lateks i rukavice za rad u čistim prostorima, kao i najčešće metode koje istraživači mikroplastike koriste za njezinu identifikaciju.
Eksperiment je oponašao uobičajenu vrstu kontakta u istraživačkom okruženju, odnosno kontakt rukavica s laboratorijskom opremom koju istraživači koriste tijekom proučavanja mikroplastike, uključujući filtre i mikroskopska stakalca. Utvrđeno je da su rukavice u prosjeku uzrokovale oko 2000 lažno pozitivnih rezultata po kvadratnom milimetru površine.
„Vrsta kontakta koju smo pokušali oponašati obuhvaća sve varijante istraživanja mikroplastike”, kaže Clough. „Ako uzorak dodirujete rukom u rukavici, vrlo je vjerojatno da unosite te stearate koji mogu dovesti do precjenjivanja rezultata.”
Istraživačice su također utvrdile da rukavice za rad u čistim prostorima ostavljaju najmanje čestica i to vjerojatno zato što se proizvode bez premaza od stearata, što im omogućuje primjenu u uvjetima ultravisoke čistoće.
Koristeći skenirajuću elektronsku mikroskopiju i mikroskopiju temeljenu na svjetlosti, istraživačice su utvrdile da je stearat vizualno nemoguće razlikovati od polietilena, plastike kojoj nalikuje. No Clough i McNeil uspjele su pronaći metode koje mogu razlikovati lažno pozitivne rezultate uzrokovane rukavicama od mikroplastike u okolišu, što može pomoći istraživačima da ponovno analiziraju potencijalno kontaminirane skupove podataka.
„Za istraživače mikroplastike koji imaju ovakve kompromitirane skupove podataka još uvijek postoji nada da ih mogu oporaviti i utvrditi stvarnu količinu mikroplastike”, kaže Clough.
Istraživačice ističu da njihova studija naglašava važnost kemičara u području istraživanja mikroplastike jer oni mogu prepoznati razliku u kemijskoj strukturi plastike i drugih onečišćivača. „Ovo je područje vrlo zahtjevno za rad jer je plastika posvuda. Zato su nam u ovom području potrebni kemičari i ljudi koji razumiju kemijsku strukturu“, zaključuje Anne McNeil.
Stjepan Felber | Ekovjesnik